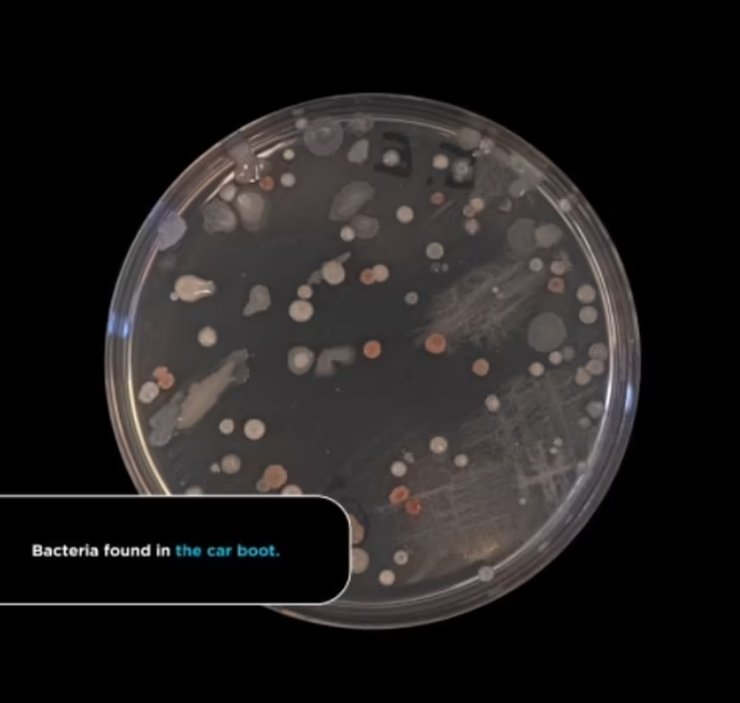
бактерии, автомобиль, машина, багажник
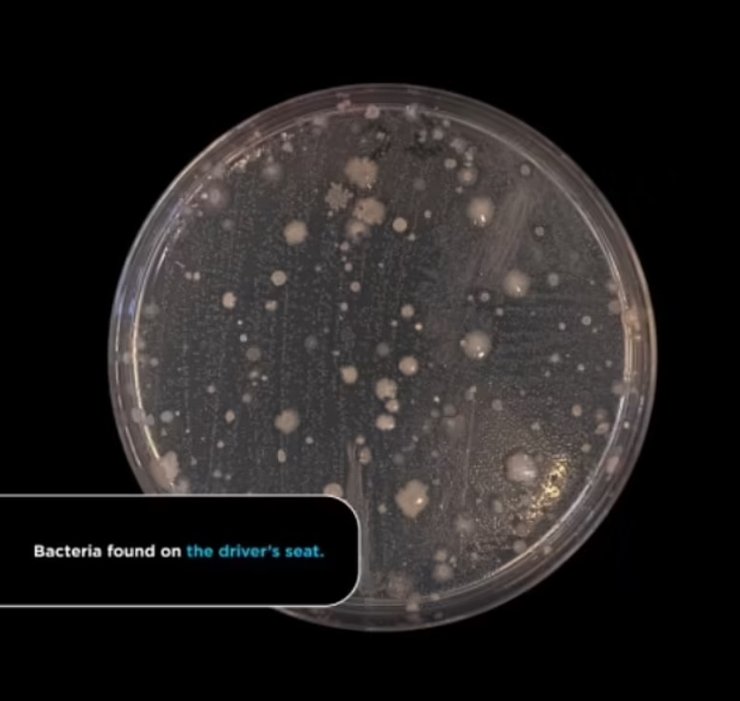
бактерии, автомобиль, сиденье, водитель
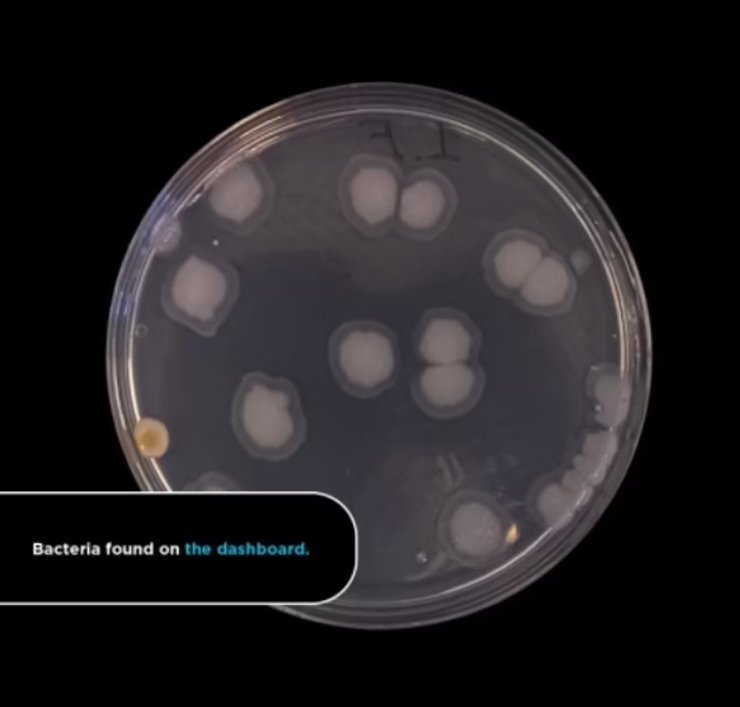
бактерии, автомобиль, приборная доска

В салонах автомобилей больше микробов, чем на крышках унитазов, – исследование

Исследователи назвали шесть самых грязных мест в салонах автомобилей, которым уступает даже туалет.
Салоны автомобилей оказались грязнее туалетов, являясь домом для целых колоний вредных бактерий. Об этом сообщает Daily Mail.
Исследование было проведено учеными из Астонского университета, команда брала образцы из салонов автомобиле с "разной историей", чтобы определить уровни бактериального загрязнения. Самым грязным местом оказался багажник автомобилей, за которым последовали водительское сиденье, рычаг переключения передач и заднее сиденье.
Также обнаружилось, что пробы из шести разных мест в салоне автомобиля были грязнее, чем пробы с крышек и сидений унитазов. Исследование показало, что в багажнике авто находится большое количество бактерий E.coli, более известных как фекальные бактерии.
Такие выводы заставляют задуматься о том, стоит ли класть в багажник продукты или же перекусывать в салоне автомобиля.
"Полученные результаты впечатляют, поскольку они подтверждают мысль о том, что чем старше автомобили, тем они грязнее, несмотря на регулярные чистки", – говорит микробиолог из Астонского университета Джонатан Кокс.
В рамках исследования, ученые взяли мазки из 5 б/у автомобилей. В список вошли 17-летний Peugeot 307-SW, 9-летний Honda Jazz и 13-летний Ford Focus.
После этого, исследователи взяли мазки в двух домашних унитазах, которые не были вымыты предварительно и использовались в предыдущие 24 часа.
Мазки из шести мест в салоне автомобиля – багажнике, водительском сиденье, рычаге переключения передач, заднем сиденье, приборной панели и руле, оказались намного грязнее, чем после сидений унитаза.
В ходе эксперимента была обнаружена взаимосвязь между возрастом машины и количество бактерий в ней. Старые автомобили имели более высокую бактериальную нагрузку.
Неожиданностью для ученых стало то, что руль оказался самым чистым местом в автомобиле из всех проверенных. В этом месте наблюдалась довольно низкая бактериальная нагрузка, возможно, из-за массового использования антисептиков для рук в свете пандемии коронавируса.
"Полученные результаты говорят о том, что мы должны изменить свое отношение к автомобилям и чистоте. Например, вы бы никогда не стали есть, сидя на своем унитазе", – подытожил микробиолог.